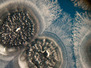

02 December 2013
The Small Print
Our trillions of ‘friendly’ gut bacteria communicate with one another and their environment by sending and receiving chemical signals. The outcomes of their socialising can affect our health both positively and negatively. But untangling and decoding the signals is difficult, like focusing on one conversation in a crowded room. Scientists have solved this problem through the unlikely means of 3D printing: custom-made structures, such as the one shown here in red, can be printed from gelatine to trap bacteria, shown in green, into virtually any arrangement. Using this technique, researchers discovered that a surrounding shell of antibiotic-resistant bacteria from the human gut prevents the death of non-resistant gut bacteria enclosed within it when treated with antibiotics. Designing 3D-printed test habitats will shed light on how bacterial interactions affect our health, potentially leading to new, more effective antibiotic treatments.
Written by
- Image by J. Connel, E. Ritschdorff, M. Whiteley and J. Shear
- The University of Texas at Austin
- Copyright held by original authors
- Research published in PNAS, September 2013
Search The Archive
Submit An Image
Like us on Facebook
Follow on Twitter
Follow on Tumblr
Follow on Instagram
What is BPoD?
BPoD stands for Biomedical Picture of the Day. Managed by the MRC Laboratory of Medical Sciences until Jul 2023, it is now run independently by a dedicated team of scientists and writers. The website aims to engage everyone, young and old, in the wonders of biology, and its influence on medicine. The ever-growing archive of more than 4000 research images documents over a decade of progress. Explore the collection and see what you discover. Images are kindly provided for inclusion on this website through the generosity of scientists across the globe.
BPoD is also available in Catalan at www.bpod.cat with translations by the University of Valencia.